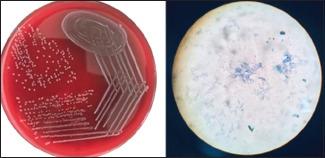

印度白喉疫情死灰复燃:来自卡纳塔克邦南部的案例研究
Diphtheria resurgence in India: A case study from south Karnataka.
作者信息
Gupta Akshita, Gujral Meher, Singh Ajay, Chawla Kiran
机构信息
Department of Microbiology, Kasturba Medical College, Manipal, Manipal Academy of Higher Education (MAHE), Manipal, Karnataka, India.
出版信息
J Family Med Prim Care. 2020 Nov 30;9(11):5776-5778. doi: 10.4103/jfmpc.jfmpc_480_20. eCollection 2020 Nov.
is a gram-positive bacillus with characteristic polar metachromatic granules. It was a significant public health problem, infecting the throat and upper airways and producing a highly potent exotoxin but with the advent of diphtheria vaccine, cases have rapidly decreased. Now over the last decade, the reemergence of this infection has been noted and case reports from India have been documented. India represents 78% of globally reported cases with significant mortality despite national immunization programs in place. This case study indicates the severity of an improperly managed case, the importance of microbiological diagnosis with a special interest in molecular detection, and reinforces a resurgence of diphtheria infection.
是一种革兰氏阳性杆菌,具有特征性的极性异染颗粒。它曾是一个重大的公共卫生问题,感染咽喉和上呼吸道并产生一种高效外毒素,但随着白喉疫苗的出现,病例迅速减少。在过去十年中,这种感染再次出现,印度已有病例报告记录在案。尽管有国家免疫计划,但印度的病例占全球报告病例的78%,死亡率很高。本病例研究表明了处理不当病例的严重性、微生物诊断尤其是分子检测的重要性,并强化了白喉感染的再次出现。